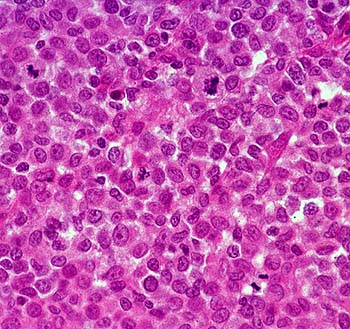
Biopsy specimen of a histiocytoma composed of sheets of round cells. Scattered mitoses are present (Hematoxylin and eosin stain, courtesy of Noah's Arkive, University of Georgia).

|

|
|
Figure 1. Schematic
indicating the proposed lineage of Langerhans cell
development from myeloid, monocytic, and lymphoid precursor
cells.
|
Incidence
Cancer is one of the
major causes of death in dogs.3, 7 There is a large amount
of clinical information regarding clinical signs, diagnosis, and
treatment of canine neoplasia; however, relatively little information
exists on the incidence of many types of cancer in this species. It is
well accepted that cutaneous neoplasms are among the most commonly
observed forms of cancer in dogs. Furthermore, cutaneous histiocytoma
has been reported to be the most common presentation of cutaneous
neoplasia, and the most commonly observed form of cancer overall.6,7
Signalment
Canine cutaneous
histiocytoma is most commonly observed in young dogs and tumor
incidence drops precipitously after three years of age. While this
tumor is most commonly observed in young dogs, most studies indicate
that it is infrequently observed in older animals. Breeds at risk
include Flatcoat Retrievers, English Bulldogs, Scottish Terriers,
Greyhounds, Boxers, and Boston Terriers.
Gross Lesions
Cutaneous histiocytomas
are generally observed by the practitioner as solitary, red,
dome-shaped, sparsely haired nodules that appear rapidly (Fig. 2).
They often are ulcerated, but are non-painful. The most common sites
of tumor development include the head, pinna, and neck, especially in
young dogs.3 More rarely, neoplasms may occur on the trunk
and extremities, and frequently involve the feet and toes of older
individuals (KSL, personal observation). Rarely, histiocytomas may
arise in multiple sites.
The metastatic
potential of histiocytomas has not been studied directly, but reports
of tumor metastasis are rare. Death due to cutaneous histiocytoma has
not been reported. It is generally accepted that this tumor does not
readily metastasize, and should be considered benign.

|

|
| Figure 2.
Histiocytomas of the pinna (left) and foot (right) appear as
red, raised, sparsely haired masses (Courtesy of Noah's Arkive,
University of Georgia). |
Diagnosis
Cutaneous histiocytomas
may be readily diagnosed using a combination of clinical signs,
signalment, and fine-needle aspiration cytology. Rarely, a
histopathologic diagnosis may be required. In biopsy sections,
histiocytomas are circumscribed, nonencapsulated dermal masses
composed of sheets of round cells. Individual cells have a round to
reniform nucleus with occasional nucleoli and moderate amounts of
cytoplasm(Fig. 3). Increased mitoses, discrete necrosis, and
infiltrates of small lymphocytes may be observed. Infrequently,
cutaneous histiocytoma may be confused histologically with
granulomatous inflammation, poorly granulated mast cell tumors,
plasmacytomas, and cutaneous lymphosarcoma.2
|
| Figure 3.
Biopsy specimen of a histiocytoma composed of sheets of round
cells. Scattered mitoses are present (Hematoxylin and eosin
stain, courtesy of Noah's Arkive, University of Georgia). |
Cytology
The various round cell tumors of dogs
have distinct cytologic characteristics that are presented in Table 1.
Additional information can be found in clerkship papers Canine
Round Cell Tumors and Mast
Cell Disease in Dogs and Cats: An Overview.
Table 1.
Cytologic features of round cell neoplasms of dogs.
| Feature |
Mast Cell Tumor |
Cutaneous Histiocytoma |
Transmissible Venereal Tumor |
Plasmacytoma |
Cutaneous Lymphoma |
| Nucleus |
Often obscured by purple granules |
Eccentric and oval to cleaved (butt cells) |
Round
Cordlike chromatin
Single nucleolus
|
Eccentric and round to oval
Binucleate and trinucleate cells
Anisokaryosis may be marked
|
Round to slightly indented nucleus
Finely stippled chromatin
|
| Nucleolus |
Not seen unless cells poorly granulated |
Inconspicuous and small nucleoli |
Single prominent, blue nucleolus |
Occasionally to infrequently observed |
Multiple nucleoli |
| Cytoplasm |
Numerous purple granules |
Abundant, pale blue, non-vacuolated cytoplasm |
Moderate to abundant, pale blue cytoplasm with distinct
vacuoles |
Moderate amount of medium to dark blue cytoplasm
Perinuclear clearing or Golgi zone
|
Small rim of dark blue, granular cytoplasm
Occasional cytoplasmic fragments seen
|
| Other Characteristics |
Granules may stain poorly with Diff Quik stain
Eosinophils may be present
|
Usually single ulcerated mass
Lymphoid infiltrates may be present
|
Mitoses may be abundant
Secondary inflammation may be present
|
Typical plasma cells may be observed |
Multiple neoplasms usually present |
The fine-needle
cytologic characteristics of canine cutaneous histiocytoma have been
well described and usually are diagnostic (Fig. 4).6
Histiocytoma cells have an eccentric, oval to reniform nucleus with
occasional nuclear clefts. The chromatin pattern is finely granular
and nucleoli are inconspicuous. Cells that contain nuclear clefts are
sometimes referred to as "butt cells" because of their
characteristic morphology (Fig. 5). The cytoplasm is abundant, lightly
basophilic, and lacks vacuoles or granules.
 |
 |
| Figure 4. Fine-needle aspirate
of a histiocytoma containing cells with a round to oval
nucleus and moderately abundant blue cytoplasm that lacks
vacuoles and granules. A binucleated cell and mitotic figure
are present (Wright stain, courtesy of Noah's Arkive,
University of Georgia). |
Figure 5. Histiocytoma cell
with a nuclear cleft and typical butt cell morphology. |
Treatment and
Prognosis
| Note: Treatment of animals should only be
performed by a licensed veterinarian. Veterinarians should
consult the current literature and current pharmacological
formularies before initiating any treatment protocol. |
Most cutaneous
histiocytomas regress spontaneously regardless of the course of
treatment pursued.6, 9 Regression of the tumor has been
correlated with infiltration of T- lymphocytes. This has been
hypothesized to be a CD-8 T-cell mediated phenomenon based on the
infiltration of this cellular subset and expression of major histocompatibility
complex class II antigens.6
Initial surgical
excision usually is curative; however, a second surgical excision may
be necessary for complete cure on rare occasions.1, 6 Due
to the high rate of surgical cure and the probability of spontaneous
regression, few studies have been done addressing alternate forms of
therapy. Infection of ulcerated lesions on the surface of the neoplasm
is probably the primary indication for surgical intervention.
Summary
Cutaneous histiocytomas
are benign round cell tumors of Langerhans cell origin. Neoplasms are
seen predominantly in young dogs, but can occur in older dogs. These
neoplasms usually appear as small, red, raised, sparsely haired
nodules that often have an ulcerated surface. They are observed most
commonly on the head and neck, but may occur on the trunk and limbs,
including the feet and toes. Diagnosis can generally be sufficiently
made on the basis of history, signalment, and fine-needle aspiration
cytology. In some instances, histopathology may be required for a
definitive diagnosis. Most histiocytomas regress spontaneously without
treatment; however, surgical excision is usually curative. These
neoplasms rarely metastasize and the prognosis for non-recurrence is
excellent.
References
1. Affolter VK, Moore P.F. 2000. Canine cutaneous and systemic
histiocytosis: Reactive histiocytosis of dermal dendritic cells. Am J
Dermatopathol 22:40-48.
2. Aiello SE, Mays A (eds). 1998. Tumors with histiocytic
differentiation. Merck Veterinary Manual, 8th ed. Merck & Co.,
Inc, Whitehouse Station, NJ, pp. 708-709.
3. Bonnett BN, Egenvall A, Olson P. 1997. Mortality in insured
Swedish dogs: Rates and causes of death in various breeds. Vet Rec
141:40-44.
4. Dee ONT, Dorn CR, Luis OH. 1969. Morphologic and biologic
characteristics of the canine cutaneous histiocytoma. Cancer Res
29:83-92.
5. Dobson JM, Samuel S, Milstein H, Rogers K, Wood JLN. 2002.
Canine neoplasia in the UK: Estimates of incidence rates from a
population of insured dogs. J Small Animal Pract 43:240-246.
6. Kipar A, Baumgartner W, Kremmer E, Frese K, Weiss E. 1998.
Expression of major histocompatibility complex class II antigen in
neoplastic cells of canine cutaneous histiocytoma. Vet Immunol
Immunopathol. 62:1-13.
7. Michell AR. 1999. Longevity of British breeds of dog and its
relationships with sex, size, cardiovascular variables and disease.
Vet Rec 145:628-629.
8. Moore PF. 1986. Characterization of cytoplasmic lysozyme
immunoreactivity as a histiocytic marker in normal canine tissues. Vet
Pathol 23:763-769.
9. Moore PF, Schrenzel MD, Affolter VK, Olivry T, Naydan D. 1996.
Canine cutaneous histiocytoma is an epidermotropic Langerhans cell
histiocytosis that expresses CD1 and specific beta 2-integrin
molecules. Am J Pathol 148:1699-1707.
10. Peters JH, Gieseler R, Thiele B, Steinbach F. 1996. Dendritic
cells from ontogenetic orphans to myelomonocytic descendants. Immunol
Today 17:273-278.
11. Shortman K, Caux C. 1997 Dendritic cell development: Multiple
pathways to natures adjuvants. Stem Cells 15:409-419.
12. Tizard IR 2000. The organs of the immune system. Vet Immunol
6:69-83.
Canine Cutaneous Histiocytoma
Josh R. Woods, DVM; Kenneth S. Latimer, DVM, PhD; Perry J. Bain DVM, PhD
Class of 2004 (Woods) and Department of Pathology (Latimer, Bain),
College of Veterinary Medicine, University of Georgia, Athens, GA 30602-7388
Web Page